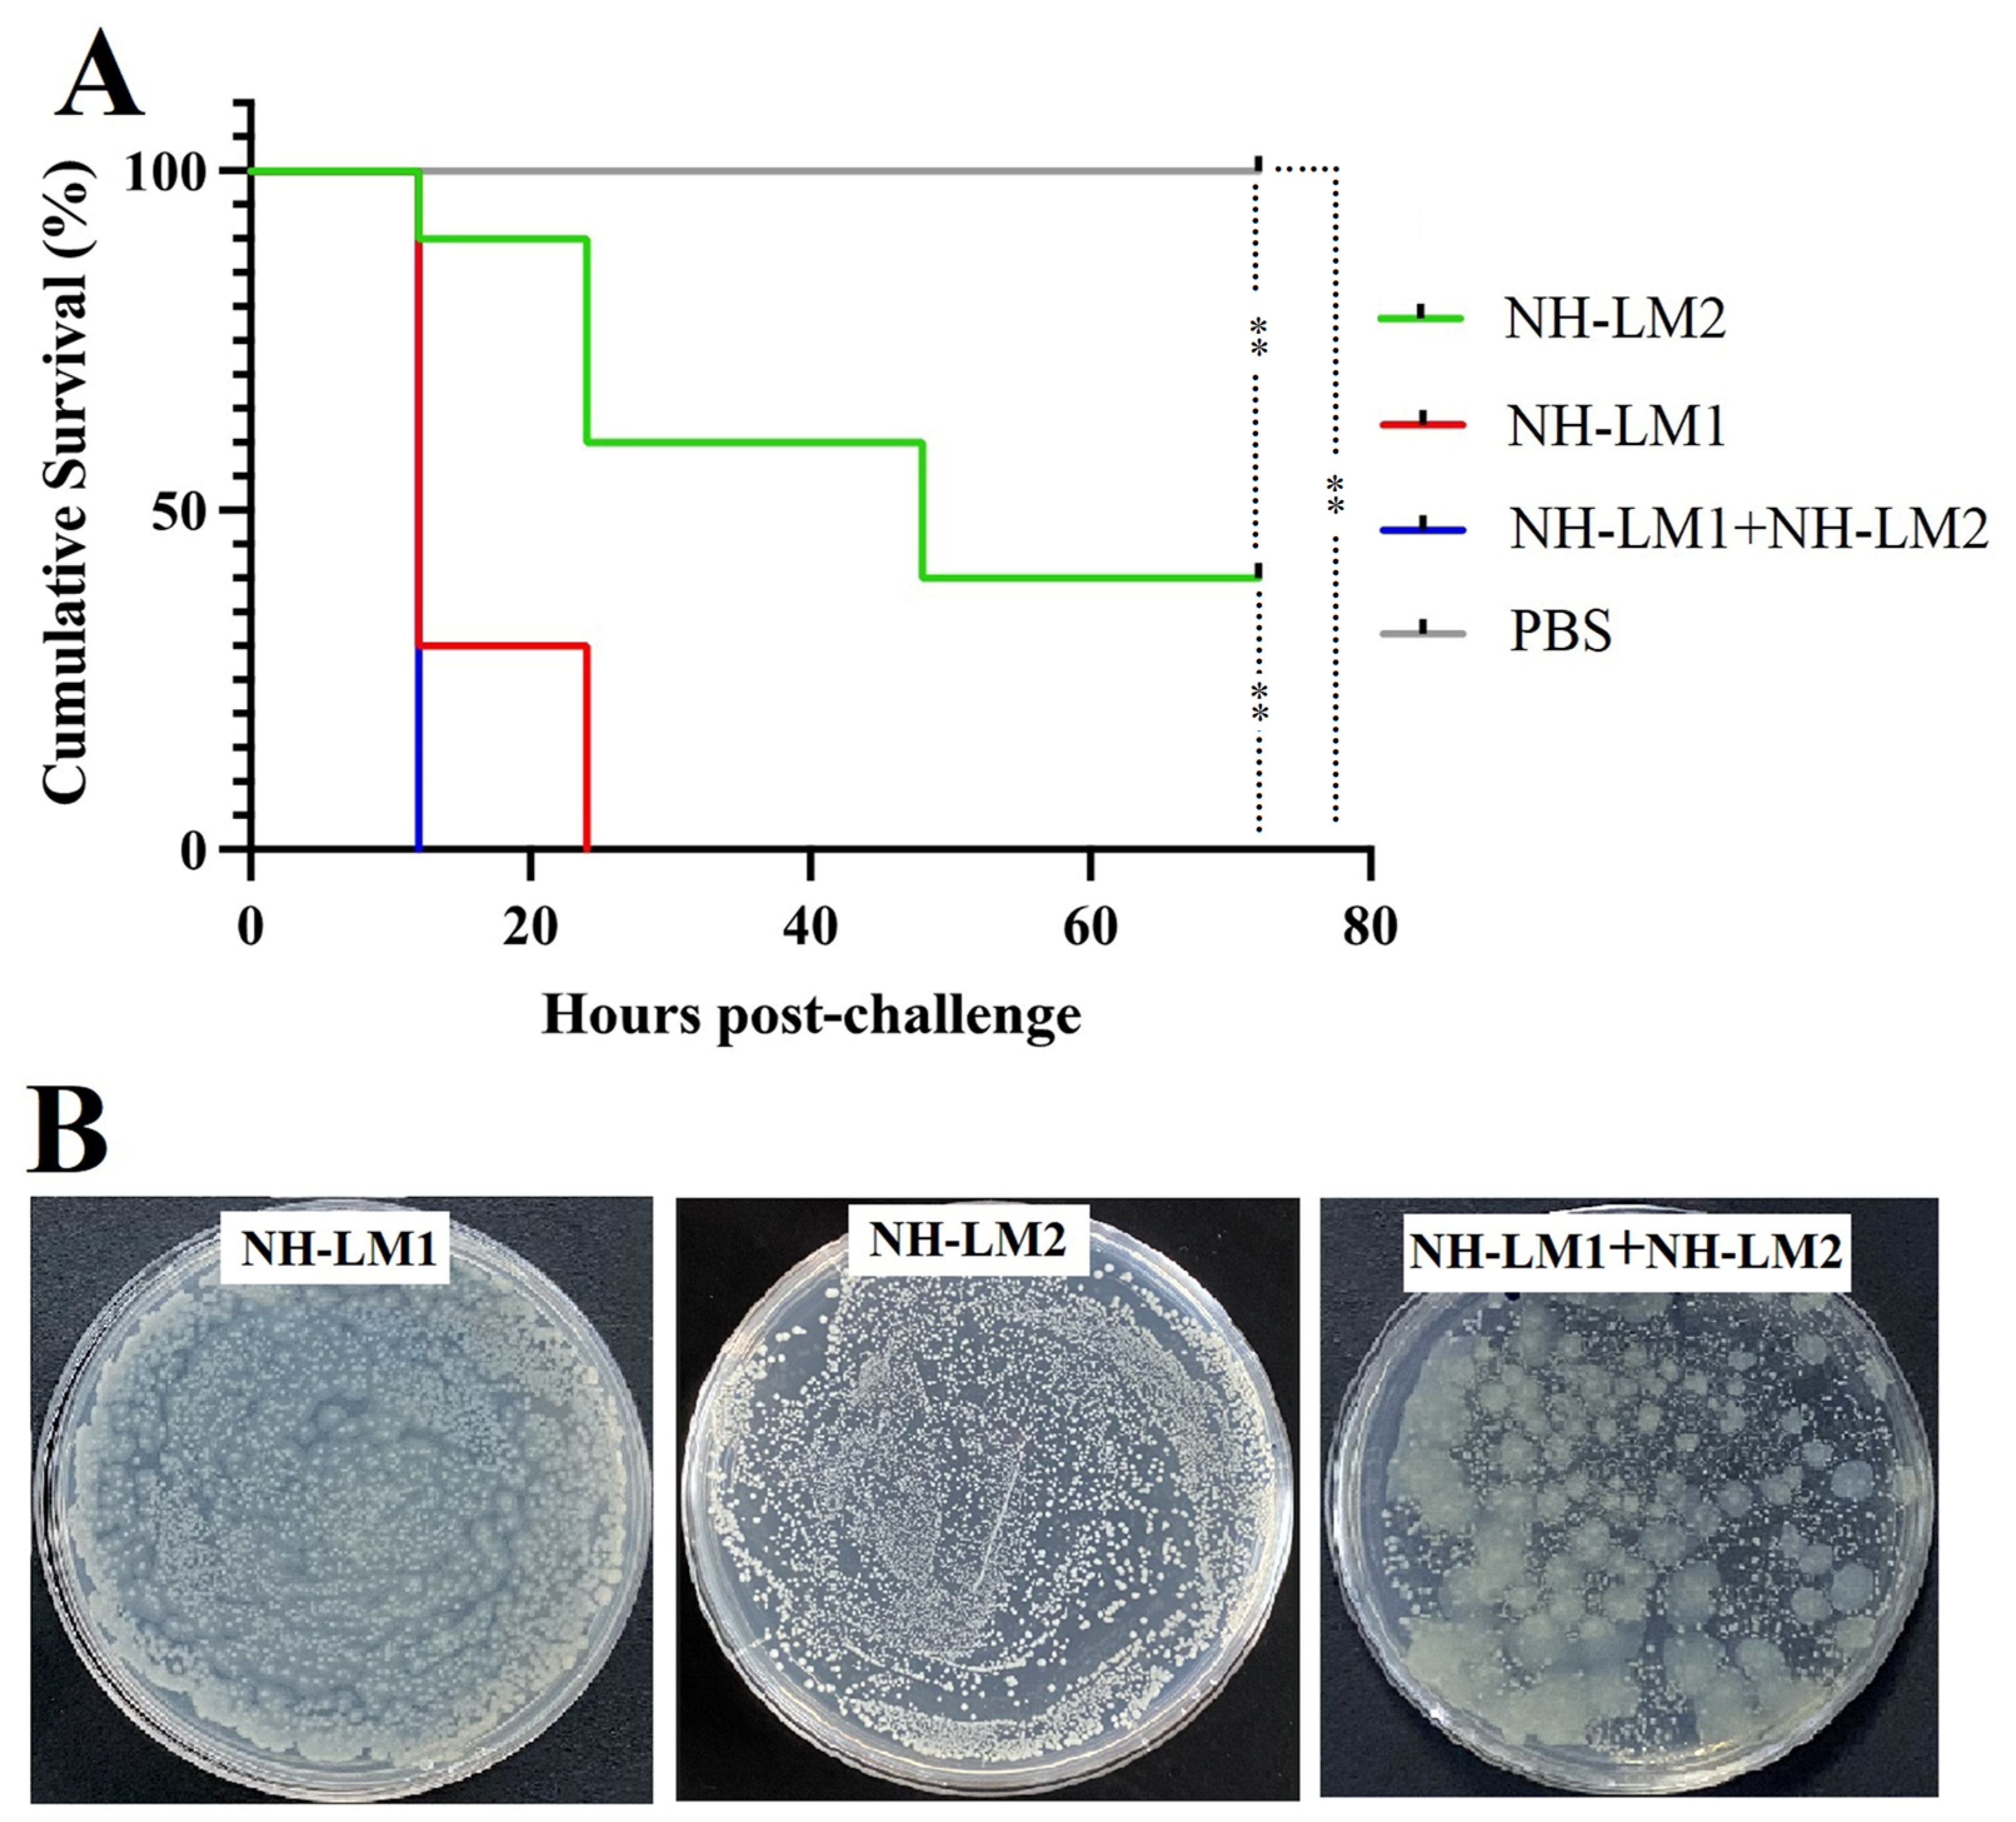
Microorganisms 12 00503 g009 Microorganisms 12 00503 g009

Abstract
Spotted sea bass (Lateolabrax maculatus) is a high-economic-value aquacultural fish widely distributed in the coastal and estuarine areas of East Asia. In August 2020, a sudden outbreak of disease accompanied by significant mortality was documented in L. maculatus reared in marine cage cultures located in Nanhuang island, Yantai, China. Two coinfected bacterial strains, namely, NH-LM1 and NH-LM2, were isolated from the diseased L. maculatus for the first time. Through phylogenetic tree analysis, biochemical characterization, and genomic investigation, the isolated bacterial strains were identified as Vibrio harveyi and Photobacterium damselae subsp. piscicida, respectively. The genomic analysis revealed that V. harveyi possesses two circular chromosomes and six plasmids, while P. damselae subsp. piscicida possesses two circular chromosomes and two plasmids. Furthermore, pathogenic genes analysis identified 587 and 484 genes in V. harveyi and P. damselae subsp. piscicida, respectively. Additionally, drug-sensitivity testing demonstrated both V. harveyi and P. damselae subsp. piscicida exhibited sensitivity to chloramphenicol, ciprofloxacin, ofloxacin, orfloxacin, minocycline, doxycycline, tetracycline, and ceftriaxone. Moreover, antibiotic resistance genes were detected in the plasmids of both strains. Extracellular product (ECP) analysis demonstrated that both V. harveyi and P. damselae subsp. piscicida can produce hemolysin and amylase, while V. harveyi additionally can produce caseinase and esterase. Furthermore, infected fish displayed severe histopathological alterations, including infiltration of lymphocytes, cellular degeneration and necrosis, and loose aggregation of cells. Artificial infection assays determined that the LD50 of P. damselae subsp. piscicida was 3 × 105 CFU/g, while the LD50 of V. harveyi was too low to be accurately evaluated. Furthermore, the dual infection of V. harveyi and P. damselae subsp. piscicida elicits a more rapid and pronounced mortality rate compared to single challenge, thereby potentially exacerbating the severity of the disease through synergistic effects. Ultimately, our findings offer compelling evidence for the occurrence of coinfections involving V. harveyi and P. damselae subsp. piscicida in L. maculatus, thereby contributing to the advancement of diagnostic and preventative measures for the associated disease.
1. Introduction
Currently, with the rapid development of intensive farming technology, aquaculture has become the fastest growing food producer in the world. Notably, the spotted sea bass (Lateolabrax maculatus) holds substantial commercial worth in both recreational fishery and the mariculture sector [1]. As a euryhaline species, L. maculatus is extensively cultivated in East Asia [2]. In recent years, the L. maculatus population has encountered escalating disease outbreaks due to the elevated density of cultures and the degradation of water quality, resulting in serious economic losses. Several pathogens, such as Aeromonas veronii, hirame rhabdovirus, and Edwardsiella piscicida, have been documented as significant contributors to the economic losses experienced by the L. maculatus industry [3,4,5].
Photobacterium damselae subsp. piscicida (formerly known as Pasteurella piscicida), a marine bacterium belonging to the family Vibrionaceae, stands out due to its extensive host range, high mortality rates, and widespread distribution, resulting in substantial economic losses in marine aquaculture worldwide [6]. P. damselae subsp. piscicida is the causative agent of pasteurellosis, which was first reported in 1963 in wild populations of Morone americanus and M. saxatilis [7]. Subsequently, it has been documented that P. damselae subsp. piscicida possesses the capability to infect a diverse range of marine fish species globally, including Sparus aurata, Dicentrarchus labrax, Tursiops truncatus, Rachycentron canadum, and Trachinotus ovatus [8,9,10,11]. The clinical manifestations observed in infected fish vary, with certain species displaying hemorrhages in the basal fin and other organs, as well as ulcerative lesions on the skin [12,13], while others exhibit septicemia along with scattered nodules on the spleen and kidney [10,14].
Vibrio harveyi, a naturally occurring bacterium in marine environments, has emerged as a formidable pathogen with substantial implications for both wild and cultured marine fish and invertebrates inhabiting warmer waters [15,16]. Diseases caused by V. harveyi have led to mass mortality across various fish species, including Epinephelus fuscoguttatus, Epinephelus lanceolatus, Paralichthys olivaceus, and Sebastes schlegeli, resulting in significant losses in aquaculture industries [17,18,19]. In fish, outbreaks of V. harveyi have been associated with various clinical manifestations, including ocular disease, gastroenteritis, cutaneous lesions, muscle necrosis, and tail rot [20]. Particularly, the presence of skin ulceration is commonly observed in V. harveyi-infected fish, leading to the attribution of V. harveyi as the primary causative agent of skin ulcer disease [20]. While numerous studies have highlighted the potential pathogenicity of V. harveyi in L. maculatus [21,22,23], there is currently no documented evidence of natural V. harveyi infection in L. maculatus.
Bacterial coinfections are a prevalent occurrence in the natural environment, arising from the invasion of multiple distinct pathogens into a single host through simultaneous or secondary infections [24]. Within aquaculture systems, fish commonly encounter a diverse array of opportunistic pathogens, with those possessing broad host ranges being more likely to locate suitable hosts compared to host-specific pathogens [25]. Coinfections can significantly alter the progression and the severity of the diseases, resulting in heightened economic losses. Nevertheless, the impact of coinfections in aquatic animals remains inadequately investigated [24]. There is evidence suggesting that V. harveyi is usually found in mixed microbial populations. For instance, V. harveyi has been identified alongside Vibro alginolyticus and Vibro parahaemolyticus in diseased Pseudosciaena crocea [26]. Additionally, recent research by Lai et al. has provided evidence of coinfections involving Cryptocaryon irritans and V. harveyi in orange-spotted grouper [27]. Coinfections involving P. damselae and other pathogens are rare, with only one suspected case of coinfection of P. damselae subsp. piscicida and Actinomyces-like organisms observed in T. truncatus [9].
In this study, we firstly report a natural bacterial coinfection with V. harveyi and P. damselae subsp. piscicida as a cause of mass mortality in marine cage-cultured L. maculatus in Nanhuang island, Yantai, China. Additionally, comprehensive investigations were conducted to evaluate the antibiotic sensitivity, biochemical characterization, genomic functions, extracellular enzymes, histopathology, and pathogenicity of these two bacterial isolates.
2. Materials and Methods
2.1. Diseased Fish Sampling and Bacterial Isolation
In August 2020, a sudden outbreak of disease accompanied by significant mortality was documented in L. maculatus (weighing between 20 and 30 g) that were reared in marine cage cultures located in Nanhuang island, Yantai, China. Diseased fish exhibiting characteristic clinical symptoms were selected, and their spleen and kidney tissues were aseptically extracted for the purpose of disease diagnosis and pathogen identification. The tissues were homogenized using sterilized seawater and subsequently inoculated onto 2216E (Haibo, Qingdao, China) agar plates, which were then incubated at a temperature of 28 °C for a duration of 24 h. Pure cultures of the two strains were obtained after three successive transfers to fresh medium, and stored at −80 °C in marine 2216E medium supplemented with 20% (v/v) sterile glycerol. The isolates were named NH-LM1 and NH-LM2, respectively.
2.2. Molecular Characterization and Phylogenetic Analysis
For 16S rRNA gene and genomic sequencing, genomic DNA of NH-LM1 and NH-LM2 were extracted using a bacterial genomic DNA extraction kit (Tiangen, Beijing, China). The concentrations of purified bacterial DNA were measured with a Nanodrop 2000 spectrophotometer (Thermo Fisher Scientific, Miami, OK, USA) and stored at −20 °C until further analysis. The 16S rRNA gene was amplified by PCR using the universal primers 27F (5′-AGAGTTTGATCCTGGCTCA-3′) and 1492R (5′-GGTTACCTTGTTACGACTT-3′) [28]. DNA sequencing was carried out by Sangon Biotech (Shanghai, China), and the 16S rRNA gene sequence was analyzed using EzBioCloud (http://eztaxon-e.ezbiocloud.net/, accessed on 12 October 2023) [29]. The phylogenetic tree was constructed by neighbor-joining [30] using the Mega software package (v10.0), and the robustness of the phylogenetic trees was estimated by bootstrap analysis based on 1000 replications.
2.3. Biochemical and Antimicrobial Resistance Characterization
The enzyme activity and carbon source were determined using the API ZYM and API 20NE systems (bioMérieux, Marcy-l’Étoile, France) according to the instructions. All API tests were performed in triplicate. The susceptibility of NH-LM1 and NH-LM2 to 30 antibiotics listed in Table 1 was tested by the Kirby–Bauer disc diffusion method [31] on 2216E agar plates using commercial antibiotic discs (Hangzhou Microbial Reagent Co., Ltd., HangZhou, China). The antibiotic sensitivity of the strains, as resistant (R), intermediate (I), or sensitive (S), was measured by the diameter of the inhibition zone around each disc according to standards suggested by the company. All tests were performed in triplicate.
Table 1.
Antibiotic susceptibilities of NH-LM1 and NH-LM2.
2.4. Genomic Sequencing and Analysis
The genomes of strains NH-LM1 and NH-LM2 were sequenced using the PacBio Sequel and Illumina NovaSeq PE150 platforms in Novogene Bioinformatics Technology Co., Ltd. (Beijing, China). PacBio reads with low quality (<500 bp) were filtered out, and long reads (>6000 bp) were selected as the seed sequence. The remaining shorter reads were aligned to generate a contiguous sequence without gaps using the SMRT portal assembly software (v5.0.1) [32]. The preliminary assembly result was further corrected using the variant Caller module of the SMRT Link software (v5.0.1) [32], and then refined using Illumina reads aligned by the Burrows–Wheeler Aligner (BWA) (v0.7.12) [33]. The authenticity of the genome was verified using CheckM (Version 1.1.3) [34], and the 16S rRNA gene sequence from the genome was compared with the 16S rRNA gene sequence to ensure its authenticity [35]. The genome component and gene functions were subsequently predicted using the NCBI Prokaryotic Genome Annotation Pipeline (PGAP) [36]. Circular genome maps were generated using Circos to display annotation information [37]. Functional annotations were conducted against 6 databases, i.e., KEGG (Kyoto Encyclopedia of Genes and Genomes), COG (Clusters of Orthologous Groups), NR (Non-Redundant Protein Database databases), Swiss-Prot, GO (Gene Ontology), and TrEMBL. Additionally, the presence of virulence factors was predicted using the Pathogen–Host Interactions database (PHI) and Virulence Factors database (VFDB) [38,39]. Antibiotic resistance genes were analyzed with Antibiotic Resistance Genes Database (ARDB) and the Comprehensive Antibiotic Research Database (CARD) [40,41].
2.5. Determination of Extracellular Enzymes and Hemolytic Effect
The extracellular enzymatic activities, including phospholipase, lipase, amylase, hemolysin, and urease, of NH-LM1 and NH-LM2 were assessed following previously established protocols [42,43]. In summary, NH-LM1, NH-LM2, and Escherichia coli DH5α were cultured in 2216E media to an OD600 of 0.8, then the cells were washed and re-suspended in PBS to 1 × 108 CFU/mL. The 2216E agar plates supplemented with 2% starch, 1% gelatin, 1% starch, and 1% tween-80 were prepared accordingly. Additionally, a sheep blood agar plate (Hope Bio, Qingdao, China) was used for the hemolytic assay. Five microliters of each bacterial suspension were spot-inoculated on the respective plates, and incubated at 28 °C for 24 h. The test was performed in triplicate.
2.6. Experimental Infection
2.6.1. Experimental Fish
Clinically healthy L. maculatus (average weight 14.7 g) were purchased from a commercial fish farm located in Yantai, Shandong province. The fish were then maintained in aerated seawater at 20 °C. Prior to any experimental procedures, the fish were acclimated in the laboratory for a duration of 2 weeks and verified to be free of pathogenic bacteria. For tissue collection, the fish were euthanized using an excessive dose of tricaine methanesulfonate (Sigma, St. Louis, MO, USA). The live animal research was conducted according to the guidelines of “Regulations for the Administration of Affairs Concerning Experimental Animals” promulgated by Shandong Province. The study, including the experiments involving live animals, was approved by the Ethics Committee of Yantai University.
2.6.2. Single Bacterial Infection and Quantitation of Bacteria in Tissues
For the in vivo infection experiment, strain NH-LM1 or NH-LM2 was cultured in 2216E medium to an OD600 of 0.8. The cells were then washed and re-suspended in PBS to obtain various concentrations (ranging from 1 × 101 to 1 × 108 colony-forming units (CFU)/mL). A total of ninety healthy juvenile L. maculatus were randomly assigned into nine groups (groups 1 to 9), and intraperitoneally injected with either 100 μL of the bacterial pathogen or PBS. Accumulative mortalities were recorded over a period 14 days, and dead fish were randomly selected for bacteria isolation and 16S rDNA sequencing verification. The lethal dose (LD50) values were measured by Karber’s method [44].
For tissue infection analysis, bacterial strains’ NH-LM1 or NH-LM2 were cultured as above and then re-suspended in PBS to achieve concentrations of 10 × LD50. A total of fifteen healthy juvenile L. maculatus were randomly divided into three groups and i.p. injected with 100 μL of NH-LM1, NH-LM2, or PBS, respectively. At 12 h post-injection (hpi), the fish were euthanized and the bacterial counts in the liver, spleen, kidney, brain, and blood were determined by plate counts.
2.6.3. Coinfection with Strains NH-LM1 and NH-LM1
For coinfection analysis, strains NH-LM1and NH-LM2 were cultured in 2216E until reaching an optical OD600 of 0.8, and re-suspended in PBS to 6.0 × 107 CFU/mL and 1.0 × 105 CFU/mL, respectively. A total of eighty healthy juvenile L. maculatus were randomly distributed into four groups (groups A to D); group A was challenged with 100 μL of NH-LM1, group B was challenged with 100 μL of NH-LM1, group C was challenged with 100 μL of NH-LM1 and NH-LM2, and group D was injected with 100 μL of PBS. Accumulative mortalities were recorded for 14 d post-infection and the existence of NH-LM1 or NH-LM2 were confirmed by bacterial isolation and 16S rDNA analysis.
2.7. Histopathological Observations
L. maculatus were challenged with NH-LM1 or NH-LM2 as described above. The dying fish were euthanized using an excessive dose of tricaine methanesulfonate. Subsequently, liver, spleen, kidney, and brain were aseptically collected from the fish, trimmed to the appropriate dimensions, and fixed in 10% (v/v) neutral buffered formalin for at least 24 h. Additionally, portions of the liver, spleen, kidney, and brain were subjected to plate cultivation and 16S rRNA gene sequencing to confirm that NH-LM1 or NH-LM2 infection was the primary etiological factor of the disease. For histopathological assay analysis, the fixed specimens underwent dehydration through a graded alcohol series and were subsequently embedded in paraffin wax. Subsequently, paraffin sections with a thickness of 5 μm were generated using a Leica™ microtome. These sections were then stained with hematoxylin and eosin (H&E) and examined under a light microscope for observations (Leica DM1000, Hamburg, Germany).
2.8. Statistical Analysis
All statistical analyses were performed using the SPSS software (SPSS Inc., Chicago, IL, USA) (v23.0). Survival was estimated by the Kaplan–Meier method and compared by the log-rank test; analysis of variance (ANOVA) was used for another analysis. In all cases, the significance level was defined as p < 0.05.
3. Results
3.1. Clinical Symptoms of Naturally Infected Fish
The naturally infected L. maculatus displayed clinical manifestations including anorexia, lethargy, and extensive ulceration on the body surface, with some ulcers penetrating into the muscular tissue. Apart from the ulceration, no additional external symptoms were observed. During necropsy, mild ascites was detected in the abdominal cavity. Certain fish exhibited characteristic clinical lesions, such as hemorrhaging and congestion in the liver, kidney, and intestines, as well as darkening of the spleen, jejunum, and empty stomach (Figure 1).
Figure 1.
Clinical symptoms of natural coinfection in Lateolabrax maculatus. (A) Obvious clinical symptoms of natural Vibrio harveyi NH-LM1 and Photobacterium damselae NH-LM2 coinfection in L.maculatus (hollow arrow). (B) Visceral lesion features of the diseased fish, arrows indicted the diseased region.
3.2. Isolation and Identification of the Pathogens
After incubating the diseased fish tissue homogenate at a temperature of 28 °C for a duration of 24 h, the presence of two bacterial strains exhibiting distinct morphological and colony size characteristics was observed. These strains were designated as NH-LM1 and NH-LM2. Subsequently, pure cultures of NH-LM1 and NH-LM2 were obtained through three consecutive transfers to fresh 2216E agar plates. To ensure long-term preservation, the strains were stored at a temperature of −80 °C in a marine 2216E broth medium supplemented with 20% (v/v) glycerol. The identification of the bacterial isolates was confirmed by sequencing the 16S rDNA gene, and the resulting sequences were submitted to GenBank under the accession numbers PP130145 and PP130146. The phylogenetic tree exhibited that strain NH-LM1 was clustered together with known species of V. harveyi, and most closely related to strain V. harveyi XC141029T, meanwhile, strain NH-LM2 was grouped together with known species of P. damselae subsp. piscicida, and most closely related to strain P. damselae subsp. piscicida NCIMB 2058T (Figure 2).
Figure 2.
The neighbor-joining phylogenetic tree based on 16S rRNA gene sequences showing the phylogenetic positions of (A) Vibrio harveyi NH-LM1 and (B) Photobacterium damselae subsp. piscicida NH-LM2. Bootstrap values >50% based on 1000 replications are shown at branching points. Terasakiispira papahanaumokuakeensis PH27AT (GenBank accession NR137414.1) was used as an outgroup. Scale bar: 0.05 substitutions per nucleotide position. Bold font indicated the isolated strains of this study.
3.3. Biochemical Characteristics
The biochemical characterizations of V. harveyi NH-LM1 and P. damselae subsp. piscicida NH-LM2 were performed using the API ZYM and API 20NE systems. The results showed that V. harveyi NH-LM1 can utilize l-tryptophan, dextrose, l-arginine, urea, aescin iron citrate, gel (bovine source), and 4-nitrobenzene-β-d-galactopyranoside; and P. damselae subsp. piscicida NH-LM2 can utilize dextrose, l-arginine, urea, aescin iron citrate, and 4-nitrobenzene-β-d-galactopyranoside. The API ZYM enzymatic profiles showed that V. harveyi NH-LM1 and P. damselae subsp. piscicida NH-LM2 were both positive for alkaline phosphatase, esterase (C4), esterase lipase (C8), lipase (C14), leucine arylamidase, valine arylamidase, cystine arylamidase, acid phosphatase, naphthol-AS-BI-phosphohydrolase, oxidase, and catalase. In addition, V. harveyi NH-LM1 was also positive for trypsin, chymotrypsin, α-glucosidase, and N-acetyl-β-glucosaminidase (Table S1).
3.4. Antibiotic Sensitivity
The sensitivity of the two strains was assessed using the disc diffusion method on 2216EA plates with antibiotic discs to evaluate their response to 30 antibiotics. The size of the inhibition zone surrounding each disc was used to determine the strains’ antibiotic sensitivity, categorized as resistant, intermediate, or sensitive. The findings revealed that V. harveyi NH-LM1 exhibited resistance to 12 antibiotics, including clindamycin, polymyxin B, vancomycin, cefoperazone, cefradine, cefamezin, cephalexin piperacillin, carbenicillin, ampicillin, oxacillin, and penicillin. P. damselae NH-LM2 was resistant to 10 antibiotics, i.e., clindamycin, vancomycin, midecamycin, neomycin, gentamicin, erythromycin, carbenicillin, ampicillin, oxacillin, and penicillin. Both strains were resistant to clindamycin, vancomycin, cefamezin, carbenicillin, ampicillin, oxacillin, and penicillin (Table 1).
3.5. Genomic Analysis
Genomic analysis indicated that strain V. harveyi NH-LM1 contains two circular chromosomes of 2,355,947 bp and 3,694,728 bp (Figure 3), and six circular plasmids of 101,750 bp, 126,749 bp, 57,915 bp, 65,786 bp, 75,229 bp, and 81,481 bp, in which 6136 genes were predicted (Figure S1; Table 2). The predicted numbers of 5S rRNA, 16S rRNA, 23S rRNA, and tRNA sequences were 12, 11, 11, and 129, respectively (Table 2). In addition, 26 genomics islands, two prophages, one CRISPR, and 539 secreted proteins were also detected in the genome of V. harveyi (Table 2). Genomic analysis indicated that strain P. damselae subsp. piscicida NH-LM2 contains two circular chromosomes of 1,302,242 bp and 3,176,321 bp (Figure 4), and three circular plasmids of 114,771 bp, 114,897 bp, and 185,744 bp, in which 4317 genes were predicted (Figure S2; Table 2). The predicted numbers of 5S rRNA, 16S rRNA, 23S rRNA, and tRNA sequences were 21, 19, 19, and 211, respectively (Table 2). In addition, five genomics islands, two prophages, four CRISPR, and 338 secreted proteins were also detected in the genome of P. damselae subsp. piscicida NH-LM2 (Table 2). The distributions of the COG categories of strains NH-LM1 and NH-LM2 are shown in Figure 3 and Figure 4 and Tables S2 and S3.
Figure 3.
Circular maps of Vibrio harveyi NH-LM1 chromosome 1 and chromosome 2. The base pairs are indicated outside the outer circle (circle 1). Circles 1 to 6 represent the coding genes, COG annotation, KEGG annotation, GO annotation, noncoding RNA (ncRNA), and GC content, respectively. (A) Chromosome 1, (B) Chromosome 2.
Table 2.
Summary of the genome information of strains NH-LM1 and NH-LM2.
Figure 4.
Circular maps of Photobacterium damselae subsp. piscicida NH-LM2 chromosome 1 and chromosome 2. The base pairs are indicated outside the outer circle (circle 1). Circles 1 to 6 represent the coding genes, COG annotation, KEGG annotation, GO annotation, noncoding RNA (ncRNA), and GC content, respectively. (A) Chromosome 1, (B) Chromosome 2.
3.6. Pathogenic Genes Analysis
The whole genome of strain NH-LM1 was subjected to comprehensive analysis in order to identify its functional genes associated with pathogenicity. Utilizing the PHI and VFDB databases, the pathogenicity analysis successfully identified 587 and 532 genes related to pathogenicity, respectively. Further classification analysis using the PHI phenotype classification system revealed that the majority of virulence-related genes fell into the categories of reduced virulence (356 genes), loss of virulence (22 genes), and increased virulence (22 genes) (Figure 5). The ARDB database analysis identified 23 genes associated with antibiotic resistance, primarily targeting specific antibiotics of aminoglycoside, macrolide, glycylcycline, penicillin, chloramphenicol, enoxacin, norfloxacin, fluoroquinolone, tetracycline, and trimethoprim. The analysis of the CARD database yielded the identification of 84 genes that are associated with antibiotic resistance, and these findings were corroborated by the alignment of their target antibiotics with the results obtained from the ARDB analysis. Furthermore, the CARD analysis provided insights into the resistance mechanism of NH-LM1, which encompassed antibiotic efflux, reduced permeability to antibiotics, antibiotic inactivation, and alteration of antibiotic targets. Additionally, our investigation also revealed the presence of seven genes encoded by the plasmid that are linked to antibiotic inactivation, with a particular focus on aminoglycosides and cephalosporins.
Figure 5.
Pathogen host interactions (PHI) annotation of the functional genes of (A) Vibrio harveyi NH-LM1 and (B) Photobacterium damselae subsp. piscicida NH-LM2. Numbers above each column indicate the gene numbers of different pathogen PHI phenotypic mutant types.
The pathogenicity genes of NH-LM2 were also analyzed. PHI and VFDB analyses detected 484 and 329 genes related to pathogenicity, respectively. The PHI phenotype classification analysis revealed that the virulence-related genes were mainly classified into the phenotypic mutant types of reduced virulence (287 genes), loss of virulence (21 genes), and increased virulence (27 genes) (Figure 5). Additionally, analysis conducted using the ARDB database identified 21 genes linked to antibiotic resistance, primarily targeting aminoglycoside, macrolide, glycylcycline, beta_lactam, chloramphenicol, fluoroquinolone, streptogramin, tetracycline, trimethoprim, kanamycin, ciprofloxacin, and norfloxacin. The CARD database analysis detected 60 genes associated with antibiotic resistance, and these findings were consistent with the analysis results obtained from the ARDB. Furthermore, the CARD analysis also provided insights into the resistance mechanism of NH-LM2, which includes antibiotic efflux, reduced permeability to antibiotics, antibiotic inactivation, and antibiotic target replacement/alteration. Additionally, we identified six genes encoded by the plasmid that are linked to antibiotic target replacement and antibiotic efflux.
3.7. Determination of Extracellular Enzymes and Hemolytic Activities
The hemolytic activity, as well as the presence of lytic enzymes such as caseinase, esterase, amylase, and gelatinase in strains NH-LM1 and NH-LM2 were analyzed using 2216E plates supplemented with the corresponding substrates. The results of the extracellular enzymes and hemolytic activity are presented in Figure 6. NH-LM1 exhibited β-hemolysin activity and was capable of producing caseinase, amylase, and esterase, while NH-LM2 demonstrated α-hemolysin activity and produced amylase.
Figure 6.
The extracellular enzyme test results of strains NH-LM1 and NH-LM2. The hemolytic activity, as well as the presence of lytic enzymes, including caseinase, esterase, amylase, and gelatinase was analyzed using 2216E plates supplemented with sheep blood, tween-80, casein, gelatin, and starch, respectively. Control: Escherichia coli DH5α.
3.8. Single Experimental Infection with V. harveyi NH-LM1 or P. damselae Subsp. Piscicida NH-LM2
The experimental infection assays showed that mortality was observed in L. maculatus infected with either V. harveyi NH-LM1 or P. damselae subsp. piscicida NH-LM2 within 24 h, and reached the peak within 48 h. No diseased or dead fish were observed after the 48 h mark. Additionally, the presence of either V. harveyi NH-LM1 or P. damselae subsp. piscicida NH-LM2 was confirmed through the re-isolation of the pathogens from the experimentally infected fish, as evidenced by observations of colonial morphology and 16S rDNA sequencing. These findings provide strong evidence that the isolated strains of V. harveyi NH-LM1 and P. damselae subsp. piscicida NH-LM2 are indeed the causative agents of the L. maculatus infection. The results of the pathogenicity study showed that the challenged fish started to die from 12 h, and that 1.0 × 104, 1.0 × 103, 1.0 × 102, and 1.0 × 101 CFU/mL of V. harveyi NH-LM1 all caused 100% mortality within 48 h; and 9.0 × 107, 6.0 × 107, 3.0 × 107, and 1.0 × 106 CFU/mL of P. damselae subsp. piscicida NH-LM2 caused 100%, 60%, 20%, and 0% mortality within 48 h, respectively (Figure 7). The calculated LD50 of P. damselae subsp. piscicida NH-LM2 to L. maculatus was 3 × 105 CFU/g, whereas the LD50 of V. harveyi NH-LM1 could not be calculated. A tissue infection assay showed that both NH-LM1 and NH-LM2 were capable of infecting various organs including the liver, spleen, kidney, brain, and blood. Notably, the spleen and kidney exhibited the highest susceptibility to infection (Figure 8).
Figure 7.
Cumulative survival of Lateolabrax maculatus following Photobacterium damselae subsp. piscicida NH-LM2 infection. L. maculatus were challenged with different concentrations of P. damselae subsp. piscicida NH-LM2 or PBS (control), and the mortalities were observed every 12 h.
Figure 8.
Tissue distributions of Vibrio harveyi NH-LM1 or Photobacterium damselae subsp. piscicida NH-LM2 in infected Lateolabrax maculatus. L. maculatus artificially challenged with NH-LM1 (A) or NH-LM2 (B), and the numbers of recovered bacteria in brain, blood, liver, spleen, and kidney were determined. Data are the means of three independent experiments and are presented as means ± SEM. Different letters on the bars denote the statistical significance (p < 0.05).
3.9. Coinfection with V. harveyi NH-LM1 and P. damselae Subsp. Piscicida NH-LM2
In order to validate the occurrence of artificial coinfection, a challenge experiment was conducted using V. harveyi NH-LM1 and/or P. damselae subsp. piscicida NH-LM2 in L. maculatus. The cumulative mortality rate of fish challenged with P. damselae subsp. piscicida NH-LM2 reached 60% within 48 h, while the cumulative mortality rate of fish challenged with V. harveyi NH-LM1 reached 100% within 24 h. Remarkably, the coinfected fish experienced a cumulative mortality rate of 100% within 12 h (Figure 9A). The mortality rate associated with coinfection was found to be higher compared to that of single P. damselae subsp. piscicida NH-LM2 infection, and the time to death was shorter in cases of coinfection compared to single challenges (Figure 9A). Additionally, both V. harveyi NH-LM1 and P. damselae subsp. piscicida NH-LM2 were successfully re-isolated from the head kidney of deceased L. maculatus, regardless of whether they were administered as a co-challenge or a single challenge (Figure 9B). In summary, the results indicate that coinfection with V. harveyi NH-LM1 and P. damselae subsp. piscicida NH-LM2 leads to an increased pathogenicity in L. maculatus.
Figure 9.
Cumulative survival of Lateolabrax maculatus following Vibrio harveyi NH-LM1 and/or Photobacterium damselae subsp. piscicida NH-LM2 infection. L. maculatus were challenged with V. harveyi NH-LM1, P. damselae subsp. piscicida NH-LM2, V. harveyi NH-LM1 + P. damselae subsp. piscicida NH-LM2, or PBS (control). The mortalities were observed every 12 h (A), and the bacterial recovery was analyzed by plate culture (B). Significance was determined with the log-rank test. ** p < 0.01.
3.10. Pathological Analysis of Artificially Infected Fish
Compared with the control group, the histopathological examination of L. maculatus infected with P. damselae subsp. piscicida NH-LM2 revealed notable alterations: the liver cells lost their complete polygonal structure, display cell swelling, membrane dissolving, and nuclear fragmentation (indicated by blue arrow), in addition, fibroblast proliferation was also observed (Figure 10B, black arrow); lymphocyte infiltration (black arrow) and cellular vacuolar degeneration (evidenced by nuclear fragmentation and dissolution) (Figure 10E, red arrow) occurred in the spleen; severe necrotic foci were observed in the renal tissue (blue arrow), accompanied by vacuolar degeneration of renal tubular epithelial cells (Figure 10H, black arrow); the tigroid body exhibited dissolution in the central region and marginalization in the periphery, while the glial cells displayed loose aggregation (Figure 10K, black arrow). A histopathological examination of L. maculatus infected with V. harveyi NH-LM1 showed that the liver cells showed vacuolar degeneration (blue arrow), karyopyknosis, cytoplasmic lysis (Figure 10C, red arrow), and congestion (Figure 10C, black arrow); the presence of blood clots (black arrow) and occurrence of empty areas were observed (Figure 10F, red arrow) in the spleen; the kidney exhibited vacuolar degeneration of renal tubular epithelial cells (black arrow), thickening of the basement membrane of the renal tubules (red arrow), and fibroblast proliferation (Figure 10I, blue arrow); and the brain displayed pathological characteristics including lymphocyte infiltration and loosely aggregated glial cells (Figure 10L, black arrow).
Figure 10.
Histological changes in Lateolabrax maculatus following Vibrio harveyi NH-LM1 or Photobacterium damselae subsp. piscicida NH-LM2 infection. (A,D,G,J) histologic sections of healthy liver, spleen, kidney and brain; (B,E,H,K) histologic section of NH-LM2 infected liver, spleen, kidney and brain; (C,F,I,L) histologic sections of NH-LM1 infected liver, spleen, kidney and brain. Scale bar = 20 μm. * bacterium, + loosely aggregated glial cells.
4. Discussion
In this study, for the first time, we reported a natural concurrent infection of V. harveyi and P. damselae subsp. piscicida in cage-cultured L. maculatus. The diseased L. maculatus exhibited pronounced ulceration on the body surface as well as hemorrhage and congestion in the viscus. The outbreak occurred during the premonsoon season, characterized by significant rainfall, fluctuating salinity levels, and elevated water temperature. These environmental factors imposed considerable stress on the cage-cultured fish, rendering them more susceptible to bacterial invasion [45].
V. harveyi has been identified as a significant contributing factor to the development of skin ulcers in Carcharhinus plumbeus, Solea senegalensis, and E. fuscoguttatus [46,47,48]. This study also observed ulceration on the body surface and muscle of naturally infected L. maculatus. However, no ulceration was observed on the body surface of artificially infected fish, whether they were singly infected or coinfected. Previous studies on P. damselae subsp. piscicida noted the presence of whitish tubercles in the kidney and spleen of R. canadum and Lates calcarifer [10,49]. In the present study, the presence of tubercles was not observed in either naturally or artificially infected L. maculatus, suggesting that the formation of granulomas may be influenced by the size and species of the infected fish. Pathological examination revealed the occurrence of cytolytic necrosis in the liver, spleen, kidney, and brain, which could potentially be attributed to the release of bacterial toxins such as hemolysin or extracellular enzymes [50]. Similar histological alterations have also been documented in other fish species infected with P. damselae subsp. piscicida, or V. harveyi [50,51].
Previous studies have indicated that the extracellular products of bacteria play a significant role in infection and serve as a direct measure of a bacterial pathogen’s virulence. V. harveyi, a known pathogen of aquatic animals, has been found to produce various extracellular products (ECPs), including hemolysins, caseinase, gelatinase, and lipase [20]. Our findings demonstrate that V. harveyi NH-LM1 exhibits α-hemolysin activity and is capable of producing amylase, caseinase, and lipase. Similarly, P. damselae subsp. piscicida may also possess extracellular products with potential implications for infection. P. damselae subsp. piscicida has been recognized as a highly dangerous bacterial pathogen in aquaculture due to its ability to infect a wide range of hosts and cause high mortality rates [52]. One significant virulence mechanism employed by P. damselae subsp. Piscicida is the production of ECPs, which include cytotoxic, caseinase, lipase, and hemolysins [10,52]. Our results showed that P. damselae subsp. Piscicida NH-LM2 exhibits β-hemolysin activity and is capable of producing amylase. Additionally, a PHI database analysis revealed 356 and 484 genes associated with pathogenicity in NH-LM1 and NH-LM2, respectively. These findings demonstrate the high virulence of strains NH-LM1 and NH-LM2 in cultured L. maculatus.
Antibiotics continue to be a cost-effective and efficient means of combating bacterial pathogens, and are widely utilized in numerous countries. However, the widespread use of these medications in clinical settings has led to the selection and dissemination of various antibiotic resistance genes (ARGs) among the microbiota [53]. The antibiotic-sensitivity test revealed that strain V. harveyi NH-LM1 was resistant to 12 antibiotics, of which, resistance to cephalosporin (vancomycin, cefoperazone, cefradine) and aminoglycoside (piperacillin) were revealed for the first time [54,55]. Numerous studies have demonstrated that the widespread prevalence of antimicrobial resistance can be partially attributed to the horizontal transfer of antibiotic resistance genes, which is typically facilitated by plasmids [56]. Notably, a genomic analysis of V. harveyi NH-LM1 revealed the presence of six plasmids, along with seven genes encoded by plasmid that associated with aminoglycoside and cephalosporin resistance. This finding suggests that antibiotic resistance genes are being horizontally transferred through plasmids. Additionally, the antibiotic-sensitivity test conducted on strain P. damselae subsp. piscicida NH-LM2 indicated resistance to 10 of the 30 antibiotics, of which, resistance to vancomycin and neomycin, and sensitive to ciprofloxacin, ofloxacin, and doxycycline were revealed for the first time [10,11].
The LD50 metric is commonly used to assess the pathogenicity of bacterial pathogens. However, there is currently no available data on the pathogenicity of V. harveyi and P. damselae subsp. piscicida towards L. maculatus. P. damselae subsp. piscicida is known to be a dangerous bacterial pathogen for marine fish, as it exhibits a wide host range and high mortality rate [52]. Wang et al. reported an LD50 value of 1.1 × 106 CFU/g for T. ovatus [11], while Liu et al. reported an LD50 value of 1.03 × 104 CFU/g for R. canadum [10]. Turbot were found to be highly susceptible to P. damselae subsp. piscicida, with a low-dose LD50 of ≤1.6 × 104 CFU/fish [49]. In this study, NH-LM2 exhibited significant pathogenicity towards L. maculatus, as evidenced by an LD50 value of 1.03 × 105 CFU/g. Previous research has also identified V. harveyi as a significant pathogen in aquatic animals, particularly fish. Various isolates of V. harveyi have been found to display varying degrees of virulence, with LD50 values ranging from 2.0 × 104 to 2.53 × 107 CFU/g of fish body weight [17,18,19]. The challenge tests conducted in this study revealed that a concentration of 1 × 101 CFU/fish of NH-LM1 resulted in 100% mortality, indicating that the LD50 of NH-LM1 towards L. maculatus was too low to be accurately evaluated. Furthermore, the mortality of fish occurred within 12 h of exposure to either of the isolates, suggesting that the infection caused by these pathogens has a short incubation period. Similar phenomena were also reported in Shewanella algae-infected tongue soles and A. veronii-infected Carassius auratus, indicating that the short incubation period contributes to the rapid progression of the disease [57,58]. These findings suggest that both strains NH-LM1 and NH-LM2 exhibit high virulence towards L. maculatus, especially the strain NH-LM1, which showed particularly extreme pathogenicity compared to the previously reported V. harveyi.
Interactions between invading pathogens have been found to synergistically alter hosts’ susceptibility and duration of infection, leading to an increased pathogenicity of the pathogens [59]. For instance, Chandrarathan et al. reported a synergistic effect in zebrafish coinfected with A. veronii and Aeromnas hydrophila, resulting in higher mortality rates [60]. Similarly, a study by Xu et al. observed elevated mortality rates in Micropterus salmoides coinfected with A. veronii and Nocardia seriolae [61]. In this study, we observed increased mortality and accelerated mortality in fish coinfected with V. harveyi and P. damselae subsp. piscicida compared to those infected with a single pathogen, thereby indicating the presence of a synergistic effect between V. harveyi and P. damselae subsp. piscicida. These synergistic effects can be attributed to the generation of multiple virulence-related factors and extracellular enzymes, as revealed through genomic and extracellular enzyme analysis. These findings suggest that certain pathogens can mutually benefit from each other, resulting in an intensified amplification of their virulence and ultimately contributing to the occurrence of disease outbreaks in aquatic animals [24].
In this study, the outbreak of the disease was recorded in summer, characterized by significant rainfall, fluctuating salinity levels, and elevated water temperature. Reduced water quality and dramatic shifts in environmental parameters, including turbidity, temperature, oxygen levels, salinity, pH, and organic matter content, are often blamed for infectious disease outbreaks in production aquaculture systems [62,63]. However, in this study, the main environmental factors were not well recorded due to the constraints in sampling tools and conditions. In the future, more investigations and research are imperative to elucidate the intricate interactions among V. harveyi, P. damselae subsp. piscicida, environmental factors, and the fish.
5. Conclusions
In this study, for the first time, a dual infection of L. maculatus caused by V. harveyi and P. damselae subsp. piscicida was reported and comprehensively investigated. The isolated V. harveyi and P. damselae subsp. piscicida exhibited significant pathogenicity towards L. maculatus, and the coinfection of these two bacteria resulted in heightened mortality and rapid mortality in L. maculatus. Furthermore, we elucidated the production of ECP, antimicrobial resistance, pathological alterations, and genomic characteristics of these two isolates. These findings contribute novel insights into the pathogenicity of V. harveyi and P. damselae subsp. piscicida, thereby offering valuable knowledge for the diagnosis, prevention, and medical management of fish diseases induced by coinfection with these two bacteria.
Supplementary Materials
The following supporting information can be downloaded at: https://www.mdpi.com/article/10.3390/microorganisms12030503/s1, Figure S1: Circular maps of the six plasmids of Vibrio harveyi NH-LM1. The base pairs are indicated the inside circle (Circle 1). Circle 1 represents the coding genes colored according to their functional annotations based on COG database. Circle 2, GC content; Circle 3, GC skew+ (green) and GC skew- (purple). (A–F) Plasmid 1 to 6; Figure S2: Circular maps of the three plasmids of Photobacterium damselae subsp. piscicida NH-LM2. The base pairs are indicated the inside circle (Circle 1). Circle 1 represents the coding genes colored according to their functional annotations based on COG database. Circle 2, GC content; Circle 3, GC skew+ (green) and GC skew- (purple). (A–C) Plasmid 1 to 3; Table S1: Biochemical characteristics of Vibrio harveyi NH-LM1T and Photobacterium damselae subsp. piscicida NH-LM2T; Table S2: Clusters of Orthologous Group (COG) annotations of strain NH-LM1 genome; Table S3: Clusters of Orthologous Group (COG) annotations of strain NH-LM2 genome.
Author Contributions
Conceptualization, J.Z.; Methodology, D.Z. and X.L.; Software, Y.D.; Validation, J.Z.; Formal analysis, Y.D. and X.L.; Investigation, D.Z. and B.Z.; Resources, B.Z.; Data curation, D.Z. and Y.D.; Writing—original draft, D.Z.; Writing—review & editing, J.Z.; Visualization, B.Z.; Supervision, J.Z.; Funding acquisition, X.L. and J.Z. All authors have read and agreed to the published version of the manuscript.
Funding
This work was supported by the Natural Science Foundation of Shandong Province (ZR2020MC198), the Development Plan of Youth Innovation Team in Colleges and Universities of Shandong Province (2022KJ269), the Municipal Planning Agriculture-related Projects of Yantai (2023), and the Key Laboratory of Mariculture of Ministry of Education, Ocean University of China.
Data Availability Statement
Data are contained within the article and Supplementary Materials.
Conflicts of Interest
The authors declare no conflict of interest.
References
- Sun, Y.X.; Dong, H.B.; Zhan, A.J.; Wang, W.H.; Duan, Y.F.; Xie, M.J.; Liu, Q.S.; Li, H.; Zhang, J.S. Protection of teprenone against hypoxia and reoxygenation stress in stomach and intestine of Lateolabrax maculatus. Fish Physiol. Biochem. 2020, 46, 575–584. [Google Scholar] [CrossRef]
- Yokogawa, K. Nomenclatural reassessment of the sea bass Lateolabrax maculatus (McClelland, 1844) (Percichthyidae) and a redescription of the species. Biogeography 2013, 15, 21–32. [Google Scholar]
- Wang, B.T.; Mao, C.; Feng, J.; Li, Y.; Hu, J.M.; Jiang, B.; Gu, Q.H.; Su, Y.L. A first report of Aeromonas veronii infection of the sea bass, Lateolabrax maculatus in China. Front. Vet. Sci. 2021, 7, 600587. [Google Scholar] [CrossRef]
- Seo, H.G.; Do, J.W.; Jung, S.H.; Han, H.J. Outbreak of hirame rhabdovirus infection in cultured spotted sea bass Lateolabrax maculatus on the western coast of Korea. J. Fish. Dis. 2016, 39, 1239–1246. [Google Scholar] [CrossRef]
- Hu, J.; Wang, B.; Feng, J.; Liu, C.; Jiang, B.; Li, W.; Su, Y. Edwardsiella piscicida, a pathogenic bacterium newly detected in spotted sea bass Lateolabrax maculatus in China. Aquac. Rep. 2022, 22, 100973. [Google Scholar] [CrossRef]
- Barnes, A.C.; dos Santos, N.M.; Ellis, A.E. Update on bacterial vaccines: Photobacterium damselae subsp. piscicida. Dev. Biol. 2005, 121, 75–84. [Google Scholar]
- Snieszko, S.F.; Bullock, G.L.; Hollis, E.; Boone, J.G. Pasteurella sp. from an epizootic of white perch (Roccus americanus) in Chesapeake Bay-tide water areas. J. Bacteriol. 1964, 88, 1814–1815. [Google Scholar] [CrossRef] [PubMed]
- Essam, H.M.; Abdellrazeq, G.S.; Tayel, S.I.; Torky, H.A.; Fadel, A.H. Pathogenesis of Photobacterium damselae subspecies infections in sea bass and sea bream. Microb. Pathog. 2016, 99, 41–50. [Google Scholar] [CrossRef] [PubMed]
- Di Francesco, G.; Cammà, C.; Curini, V.; Mazzariol, S.; Proietto, U.; Di Francesco, C.E.; Ferri, N.; Di Provvido, A.; Di Guardo, G. Coinfection by Ureaplasma spp., Photobacterium damselae and an Actinomyces-like microorganism in a bottlenose dolphin (Tursiops truncatus) with pleuropneumonia stranded along the Adriatic coast of Italy. Res. Vet. Sci. 2016, 105, 111–114. [Google Scholar] [CrossRef] [PubMed][Green Version]
- Liu, P.C.; Lin, J.Y.; Lee, K.K. Virulence of Photobacterium damselae subsp. piscicida in cultured cobia Rachycentron canadum. J. Basic. Microbiol. 2003, 43, 499–507. [Google Scholar] [CrossRef] [PubMed]
- Wang, R.; Feng, J.; Su, Y.; Ye, L.; Wang, J. Studies on the isolation of Photobacterium damselae subsp. piscicida from diseased golden pompano (Trachinotus ovatus Linnaeus) and antibacterial agents sensitivity. Vet. Microbiol. 2013, 162, 957–963. [Google Scholar] [CrossRef]
- Fouz, B.; Larsen, J.L.; Nielsen, B.B.; Barja, J.L.; Toranzo, A.E. Characterization of Vibrio damsela strains isolated from turbot Scophthalmus maximus in Spain. Dis. Aquat. Organ. 1992, 12, 155–166. [Google Scholar] [CrossRef]
- Wang, Y.; Han, Y.; Li, Y.; Chen, J.X.; Zhang, X.H. Isolation of Photobacterium damselae subsp. piscicida from diseasedtongue sole (Cynoglossus semilaevis Gunther) in China. Acta Microbiol. Sin. 2007, 47, 763–768. [Google Scholar]
- Romalde, J.L. Photobacterium damselae subsp. piscicida: An integrated view of a bacterial fish pathogen. Int. Microbiol. 2002, 5, 3–9. [Google Scholar] [CrossRef] [PubMed]
- Firmino, J.; Furones, M.D.; Andree, K.B.; Sarasquete, C.; Ortiz-Delgado, J.B.; Asencio-Alcudia, G.; Gisbert, E. Contrasting outcomes of Vibrio harveyi pathogenicity in gilthead seabream, Sparus aurata and European seabass Dicentrarchus labrax. Aquaculture 2019, 511, 734210. [Google Scholar] [CrossRef]
- Haldar, S.; Maharajan, A.; Chatterjee, S.; Hunter, S.A.; Chowdhury, N.; Hinenoya, A.; Asakura, M.; Yamasaki, S. Identification of Vibrio harveyi as a causative bacterium for a tail rot disease of sea bream Sparus aurata from research hatchery in Malta. Microbiol. Res. 2010, 165, 639–648. [Google Scholar] [CrossRef]
- Yii, K.C.; Yang, T.I.; Lee, K.K. Isolation and characterization of Vibrio carchariae, a causative agent of gastroenteritis in the groupers, Epinephelus coioides. Curr. Microbiol. 1997, 35, 109–115. [Google Scholar] [CrossRef]
- Pujalte, M.J.; Sitjá-Bobadilla, A.; Macián, M.C.; Belloch, C.; Álvarez-Pellitero, P.; Pérez-Sánchez, J.; Uruburu, F.; Garay, E. Virulence and molecular typing of Vibrio harveyi strains isolated from cultured dentex, gilthead sea bream and European sea bass. Syst. Appl. Microbiol. 2003, 26, 284–292. [Google Scholar]
- Won, K.M.; Park, S. Pathogenicity of Vibrio harveyi to cultured marine fishes in Korea. Aquaculture 2008, 285, 8–13. [Google Scholar] [CrossRef]
- Zhang, X.H.; He, X.; Austin, B. Vibrio harveyi: A Serious Pathogen of Fish and Invertebrates in Mariculture. Mar. Life Sci. Technol. 2020, 2, 231–245. [Google Scholar] [CrossRef]
- Guo, H.; Zhang, B.; Wang, P.; Zhao, C.; Yan, L.L.; Lin, Y.X.; Qiu, L.H. Spotted sea bass (Lateolabrax maculatus) NOD2 gene involved in the immune response against Vibrio harveyi infection. J. Fish. Dis. 2023, 46, 897–901. [Google Scholar] [CrossRef]
- Tian, Y.; Wen, H.; Qi, X.; Mao, X.B.; Shi, Z.J.; Li, J.F.; He, F.; Yang, W.Z.; Zhang, X.Y.; Li, Y. Analysis of apolipoprotein multigene family in spotted sea bass (Lateolabrax maculatus) and their expression profiles in response to Vibrio harveyi infection. Fish Shellfish Immunol. 2019, 92, 111–118. [Google Scholar] [CrossRef]
- Han, Y.L.; Hou, C.C.; Du, C.; Zhu, J.Q. Molecular cloning and expression analysis of five heat shock protein 70 (HSP70) family members in Lateolabrax maculatus with Vibrio harveyi infection. Fish Shellfish Immunol. 2017, 60, 299–310. [Google Scholar] [CrossRef]
- Kotob, M.H.; Menanteau-Ledouble, S.; Kumar, G.; Abdelzaher, M.; El-Matbouli, M. The impact of co-infections on fish: A review. Vet. Res. 2016, 47, 98. [Google Scholar] [CrossRef] [PubMed]
- Cox, F.E. Concomitant infections, parasites and immune responses. Parasitology 2001, 122, S23–S38. [Google Scholar] [CrossRef]
- Fabbro, C.; Celussi, M.; Russell, H.; Del Negro, P. Phenotypic and genetic diversity of coexisting Listonella anguillarum, Vibrio harveyi and Vibrio chagassi recovered from skin haemorrhages of diseased sand smelt, Atherina boyeri, in the Gulf of Trieste (NE Adriatic Sea). Lett. Appl. Microbiol. 2011, 54, 153–159. [Google Scholar] [CrossRef] [PubMed]
- Lai, X.; Wu, H.; Guo, W.; Li, X.; Wang, J.; Duan, Y.; Zhang, P.; Huang, Z.; Li, Y.; Dong, G.; et al. Vibrio harveyi co-infected with Cryptocaryon irritans to orange-spotted groupers Epinephelus coioides. Fish Shellfish Immunol. 2023, 139, 108879. [Google Scholar] [CrossRef]
- Lane, D.J. 16S/23S rRNA sequencing. In Nucleic Acids Techniques in Bacterial Systematics; Stackebrandt, E., Goodfellow, M., Eds.; John Wiley & Sons: Chichester, UK, 1991; pp. 115–147. [Google Scholar]
- Kim, O.S.; Cho, Y.J.; Lee, K.; Yoon, S.H.; Kimet, M.; Na, H.; Park, S.C.; Jeon, Y.S.; Lee, J.H.; Yi, H.; et al. Introducing EzTaxon-e: A prokaryotic 16S rRNA gene sequence database with phylotypes that represent uncultured species. Int. J. Syst. Evol. Microbiol. 2012, 62, 716–721. [Google Scholar] [CrossRef] [PubMed]
- Saitou, N.; Nei, M. The neighbor-joining method: A new method for reconstructing phylogenetic trees. Mol. Biol. Evol. 1987, 4, 406–425. [Google Scholar]
- Gaur, P.; Hada, V.; Rath, R.S.; Mohanty, A.; Singh, P.; Rukadikar, A. Interpretation of antimicrobial susceptibility testing using European Committee on Antimicrobial Susceptibility Testing (EUCAST) and Clinical and Laboratory Standards Institute (CLSI) Breakpoints: Analysis of Agreement. Cureus 2023, 15, e36977. [Google Scholar] [CrossRef]
- Berlin, K.; Koren, S.; Chin, C.S.; Drake, J.P.; Landolin, J.M.; Phillippy, A.M. Assembling large genomes with single-molecule sequencing and locality-sensitive hashing. Nat. Biotechnol. 2015, 33, 623. [Google Scholar] [CrossRef] [PubMed]
- Li, H.; Durbin, R. Fast and accurate short read alignment with Burrows-Wheeler transform. Bioinformatics 2010, 25, 1754–1760. [Google Scholar] [CrossRef]
- Parks, D.H.; Imelfort, M.; Skennerton, C.T.; Hugenholtz, P.; Tyson, G.W. Assessing the quality of microbial genomes recovered from isolates, single cells, and metagenomes. Genome Res. 2014, 25, 1043–1055. [Google Scholar] [CrossRef]
- Chun, J.; Oren, A.; Ventosa, A.; Christensen, H.; Arahal, D.R.; da Costa, M.S.; Rooney, A.P.; Yi, H.; Xu, X.-W.; De Meyer, S.; et al. Proposed minimal standards for the use of genome data for the taxonomy of prokaryotes. Int. J. Syst. Evol. Microbiol. 2018, 68, 461–466. [Google Scholar] [CrossRef] [PubMed]
- Tatusova, T.; DiCuccio, M.; Badretdin, A.; Chetvernin, V.; Nawrocki, E.P.; Zaslavsky, L.; Lomsadze, A.; Pruitt, K.D.; Borodovsky, M.; Ostell, J. NCBI Prokaryotic Genome Annotation Pipeline. Nucleic Acids Res. 2016, 44, 6614–6624. [Google Scholar] [CrossRef]
- Krzywinski, M.; Schein, J.; Birol, I.; Connors, J.; Gascoyne, R.; Horsman, D.; Jones, S.J.; Marra, M.A. Circos: An information aesthetic for comparative genomics. Genome Res. 2009, 19, 1639–1645. [Google Scholar] [CrossRef]
- Chen, L.H.; Xiong, Z.H.; Sun, L.L.; Yang, J.; Jin, Q. VFDB 2012 update: Toward the genetic diversity and molecular evolution of bacterial virulence factors. Nucleic Acids Res. 2012, 40, D641–D645. [Google Scholar] [CrossRef]
- Martin, U.; Rashmi, P.; Arathi, R. The Pathogen-host interactions database (PHI-base): Additions and future developments. Nucleic Acids Res. 2015, 43, D645–D655. [Google Scholar]
- Jia, B.; Raphenya, A.R.; Alcock, B.; Waglechner, N.; Guo, P.Y.; Tsang, K.T.; Lago, B.A.; Dave, B.M.; Pereira, S.; Sharma, A.N.; et al. CARD 2017: Expansion and model-centric curation of the comprehensive antibiotic resistance database. Nucleic Acids Res. 2017, 45, D566–D573. [Google Scholar] [CrossRef]
- Liu, B.; Pop, M. ARDB-antibiotic resistance genes database. Nucleic Acids Res. 2009, 37, D443–D447. [Google Scholar] [CrossRef] [PubMed]
- Zhao, Y.; Chen, C.; Gu, H.J.; Zhang, J.; Sun, L. Characterization of the genome feature and toxic capacity of a Bacillus wiedmannii isolate from the hydrothermal field in Okinawa Trough. Front. Cell Infect. Microbiol. 2019, 9, 370. [Google Scholar] [CrossRef] [PubMed]
- Wang, Z.; Du, R.B.; Sun, Q.L.; Sun, Y.Y.; Zhang, J.; Tang, Y.Z. Pontivivens ytuae sp. nov., isolated from deep sea sediment of the Mariana Trench. Int. J. Syst. Evol. Microbiol. 2021, 71, 004967. [Google Scholar] [CrossRef] [PubMed]
- Hamilton, M.A.; Russo, R.C.; Thurston, R.V. Trimmed spearman-Karber method for estimating median lethal concentrations in toxicity bioassays. Environ. Sci. Technol. 1977, 11, 714–719. [Google Scholar] [CrossRef]
- Rameshkumar, P.; Kalidas, C.; Tamilmani, G.; Sakthivel, M.; Nazar, A.A.; Maharshi, V.A.; Rao, S.K.S.; Gopakumar, G. Microbiological and histopathological investigations of Vibrio alginolyticus infection in Cobia Rachycentron canadum (Linnaeus, 1766) cultured in sea cage. Indian J. Fish. 2014, 61, 124–127. [Google Scholar]
- Bertone, S.; Gili, C.; Moizo, A.; Calegari, L. Vibrio carchariae associated with a chronic skin ulcer on a shark, Carcharhinus plumbeus (Nardo). J. Fish Dis. 1996, 19, 429–434. [Google Scholar] [CrossRef]
- Zorrilla, I.; Arijo, S.; Chabrillon, M.; Diaz, P.; Martinez-Manzanares, E.; Balebona, M.C.; Morinigo, M.A. Vibrio species isolated from diseased farmed sole, Solea senegalensis (Kaup), and evaluation of the potential virulence role of their extracellular products. J. Fish Dis. 2003, 26, 103–108. [Google Scholar] [CrossRef] [PubMed]
- Shen, G.M.; Shi, C.Y.; Fan, C.; Jia, D.; Wang, S.Q.; Xie, G.S.; Li, G.Y.; Mo, Z.L.; Huang, J. Isolation, identification and pathogenicity of Vibrio harveyi, the causal agent of skin ulcer disease in juvenile hybrid groupers Epinephelus fuscoguttatus × Epinephelus lanceolatus. J. Fish Dis. 2017, 40, 1351–1362. [Google Scholar] [CrossRef]
- Pham, T.H.; Cheng, T.C.; Wang, P.C.; Chen, S.C. Genotypic diversity, and molecular and pathogenic characterization of Photobacterium damselae subsp. piscicida isolated from different fish species in Taiwan. J. Fish Dis. 2020, 43, 757–774. [Google Scholar] [CrossRef]
- Afifi, S.; Al-Thobiati, S.; Hazaa, M. Bacteriological and histopathological studies on Aeromnas hydrophila infection of Nile Tilapia (Oreochromis niloticas) from fish farms in Saudi Arabia, Assiut. Vet. Med. J. 2000, 42, 195–205. [Google Scholar]
- Mohamad, N.; Mohd Roseli, F.A.; Azmai, M.N.A.; Saad, M.Z.; Md Yasin, I.S.; Zulkiply, N.A.; Nasruddin, N.S. Natural concurrent infection of Vibrio harveyi and V. alginolyticus in cultured hybrid groupers in Malaysia. J. Aquat. Anim. Health 2019, 31, 88–96. [Google Scholar] [CrossRef] [PubMed]
- Andreoni, F.; Magnani, M. Photobacteriosis: Prevention and diagnosis. J. Immunol. Res. 2014, 2014, 793817. [Google Scholar] [CrossRef]
- Kemper, N. Veterinary antibiotics in the aquatic and terrestrial environment. Ecol. Indic. 2008, 8, 1–13. [Google Scholar] [CrossRef]
- Kang, C.H.; Kim, Y.; Oh, S.J.; Mok, J.S.; Cho, M.H.; So, J.S. Antibiotic resistance of Vibrio harveyi isolated from seawater in Korea. Mar. Pollut. Bull. 2014, 86, 261–265. [Google Scholar] [CrossRef]
- Stalin, N.; Srinivasan, P. Molecular characterization of antibiotic resistant Vibrio harveyi isolated from shrimp aquaculture environment in the south east coast of India. Microb. Pathog. 2016, 97, 110–118. [Google Scholar] [CrossRef] [PubMed]
- Castañeda-Barba, S.; Top, E.M.; Stalder, T. Plasmids, a molecular cornerstone of antimicrobial resistance in the One Health era. Nat. Rev. Microbiol. 2024, 22, 18–32. [Google Scholar] [CrossRef] [PubMed]
- Han, Z.; Sun, J.; Lv, A.; Sung, Y.; Shi, H.; Hu, X.; Xing, K. Isolation, identification and characterization of Shewanella algae from reared tongue sole, Cynoglossus semilaevis Günther. Aquaculture 2017, 468, 356–362. [Google Scholar] [CrossRef]
- Chen, F.; Sun, J.; Han, Z.; Yang, X.; Xian, J.A.; Lv, A.; Hu, X.; Shi, H. Isolation, identification and characteristics of Aeromonas veronii from diseased crucian carp (Carassius auratus gibelio). Front. Microbiol. 2019, 10, 2742. [Google Scholar] [CrossRef]
- Abdel-Latif, H.M.; Dawood, M.A.; Menanteau-Ledouble, S.; El-Matbouli, M. The nature and consequences of co-infections in tilapia: A review. J. Fish. Dis. 2020, 43, 651–664. [Google Scholar] [CrossRef]
- Chandrarathna, H.; Nikapitiya, C.; Dananjaya, S.; Wijerathne, C.; Wimalasena, S.; Kwun, H.J.; Heo, G.-J.; Lee, J.; De Zoysa, M. Outcome of co-infection with opportunistic and multidrug resistant Aeromonas hydrophila and A. veronii in zebrafish: Identification, characterization, pathogenicity and immune responses. Fish Shellfish Immunol. 2018, 80, 573–581. [Google Scholar] [CrossRef]
- Xu, H.; Xu, R.; Wang, X.; Liang, Q.; Zhang, L.; Liu, J.; Wei, J.; Lu, Y.; Yu, D. Co-infections of Aeromonas veronii and Nocardia seriolae in largemouth bass (Micropterus salmoides). Microb. Pathog. 2022, 173, 105815. [Google Scholar] [CrossRef]
- Siddique, A.B.; Moniruzzaman, M.; Ali, S.; Dewan, N.; Islam, M.R.; Islam, S.; Amin, M.B.; Mondal, D.; Parvez, A.K.; Mahmud, Z.H. Characterization of pathogenic Vibrio parahaemolyticus isolated from fish aquaculture of the Southwest Coastal Area of Bangladesh. Front. Microbiol. 2021, 12, 635539. [Google Scholar] [CrossRef] [PubMed]
- López-Hernández, K.M.; Pardío-Sedas, V.T.; Lizárraga-Partida, L.; Williams, J.d.J.; Martínez-Herrera, D.; Flores-Primo, A.; Uscanga-Serrano, R.; Rendón-Castro, K. Environmental parameters influence on the dynamics of total and pathogenic Vibrio parahaemolyticus densities in Crassostrea virginica harvested from Mexico’s Gulf coast. Mar. Pollut. Bull. 2015, 91, 317–329. [Google Scholar] [CrossRef] [PubMed]
Disclaimer/Publisher’s Note: The statements, opinions and data contained in all publications are solely those of the individual author(s) and contributor(s) and not of MDPI and/or the editor(s). MDPI and/or the editor(s) disclaim responsibility for any injury to people or property resulting from any ideas, methods, instructions or products referred to in the content. |
© 2024 by the authors. Licensee MDPI, Basel, Switzerland. This article is an open access article distributed under the terms and conditions of the Creative Commons Attribution (CC BY) license (https://creativecommons.org/licenses/by/4.0/).